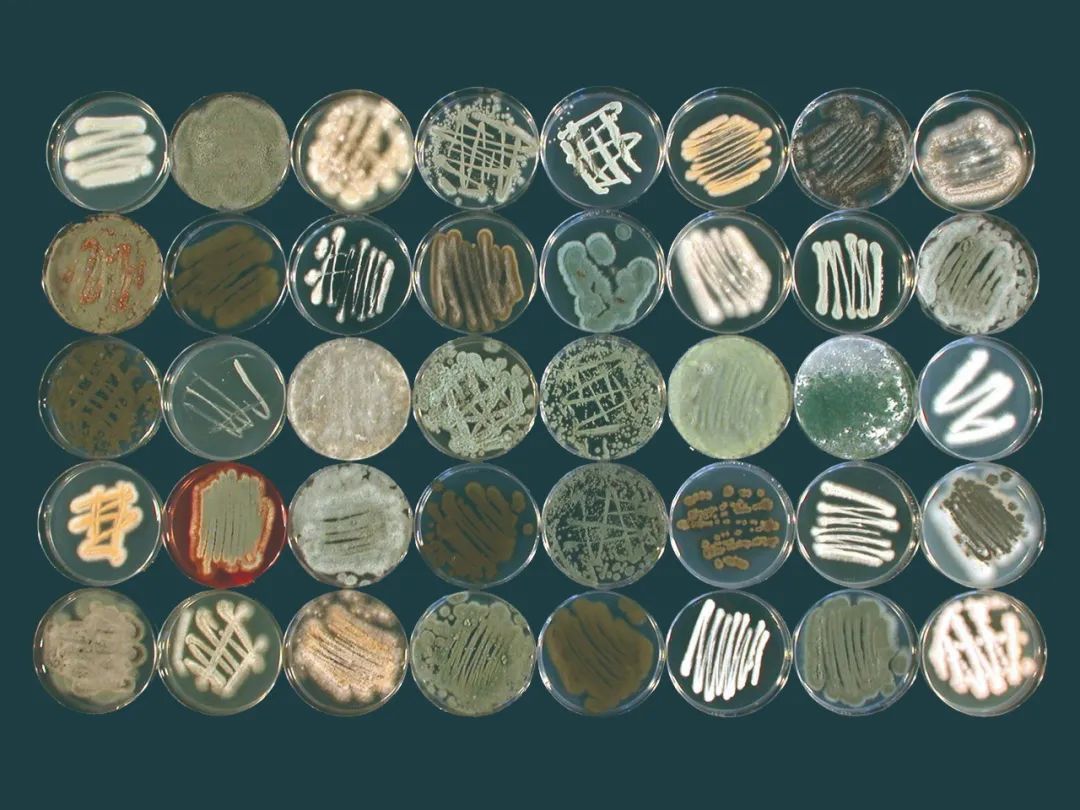

种子库里的种子发霉了
现今,全球大约有1750个种子库和基因库,它们作为世界末日的最后希望被建造在极地、高山或地下等远离人群的地方。每一颗能进入种子库的种子都是精挑细选的,它们必须健康饱满、生命力强,入库前种子都经过干燥、漂白和冷冻等处理,确保杀死其中可能携带的病虫害。种子库中常年用液氮保持-196℃的超低温,低温干燥的环境降低了种子的发芽率,这一切都是为了应对地区性或全球性灾难造成的粮食短缺,保证人类在世界末日中仍有种可种、有粮可食。

真菌有着巨大的潜藏价值
位于英国皇家植物园的种子库也有相同的目的,可是最近,科学家发现,这里的种子竟然发霉了。先不必着急,因为与种子库里存放的近4万种物种的23亿颗种子相比,此次发霉的种子不过是九牛一毛。可是古怪的是,这里的种子明明经过了挑选和消毒,为什么还会发霉呢?这些发霉的种子还能用吗?种子库里的其他种子也会发霉吗?
英国伦敦玛丽女王大学生物学家罗威娜·希尔带领的研究团队也许可以解答这些问题。研究人员将显现出发霉迹象的6种种子收集在培养皿里,用消毒剂浸泡了1710小时,将种子中可能携带的病虫害彻底杀死了,随后在正常的环境继续培养。没过多久,科学家们就收获了一个“真菌植物园”:堆叠的培养皿中长出了不同颜色、不同质地和不同形状的真菌,有的像一束满天星,有的像一朵盛开的菊花,还有的像一簇簇薰衣草……
通过提取真菌的DNA和进行比对,科学家终于知道这些真菌是什么——藏在种子体内的内生真菌。是种子将这些真菌带到种子库中来,也是种子在保护它们,使它们不被消毒剂和超低温杀死,甚至在条件适宜的时候,以身饲“菌”,使得这些真菌得以萌发。为什么种子会对真菌这样无私奉献?
无所不在的内生真菌
说起种子体内携带真菌,其实没什么值得大惊小怪。我们对根瘤菌非常熟悉,这是一类与豆类作物共生的细菌,它们群聚在豆类作物的根部,一方面靠植物供养,另一方面将空气中的氮气转化成氮肥供给植物,两者合作亲密无间,互利共生。与此相似,有一些真菌也与植物存在这样的共生关系,在长久的合作中,真菌侵入到植物体内,两者成为更亲密的合作伙伴。
收集在培养皿里的发霉种子
几乎所有的植物体内都存在内生真菌,单株植物身上能同时存在多株真菌,因此植物内生真菌分布广泛,数量众多。比如,有科学家在沉香树脂部位发现了33株内生真菌,从新疆药用植物红景天根部中也分离出19株内生真菌,前文提到的英国种子库中的6种植物种子内也发现了近200种内生真菌。
内生真菌生长过程中主要的传播形式有两种,一种是通过自身的菌丝生长进入植物子房和胚珠,当植物成熟时,内生真菌便可以借助该植物种子进行传播;另一种是其本身可以产生孢子,在外力条件如风力、雨水等作用下传播。由于不同植物分离出的内生真菌类型也存在差异,这样内生真菌就能像其他生物那样,通过交叉感染和基因交流发展出越来越多的种类。
植物与内生真菌的关系和豆科植物与根瘤菌的相似,两者是互利共生的。植物通过光合作用为内生真菌提供有机营养物,内生真菌能促进宿主植物的生长发育,还有增强植物的抗逆性、控制植物病虫害等作用,可谓是宿主植物的“保护神”。不过,内生真菌也不是不求回报的,如果宿主植物健康强壮,它就能通过光合作用为真菌提供足够的营养,但如果植株本身有问题,或是在生长过程中意外受伤甚至死亡,真菌就会把植株当做食物一样吃掉!这也是种子库中那些没能萌发的种子发霉的真正原因。
种子库中的隐藏宝藏
目前,科学家对植物内生真菌的了解并不多,对内生真菌的研究主要集中在一些经济植物上。但即使是为数不多的研究,内生真菌也展现了巨大的潜在价值。紫杉醇是第一个从植物中提取的天然化疗药物,至今仍然是肿瘤化疗药物中常见的药物之一,它对包括卵巢癌、乳腺癌、子宫癌等多种癌症都有显著的疗效,而且几乎没有副作用。可是,这样一种神奇的药物却并非人人都能用得上,因为紫杉醇来自一种稀有的树种:红豆杉。红豆杉是来自第四纪冰川时期的“活化石”,在地球上分布范围小,数量少,是公认的天然珍稀抗癌植物,紫杉醇最初就是从红豆杉的树皮和枝叶中提取出来,运用这种方法提取过紫杉醇后,红豆杉就会死去。更困难的是,紫杉醇在植物体中的含量相当低,大约13.6千克的树皮才能提出1克的紫杉醇,治疗一个卵巢癌患者需要3~12棵百年以上的红豆杉,这让紫杉醇变得更加稀少难得。
种子库
不过,这个困境最近有了转机:1993年,人们首次从短叶红豆杉中分离得到一株能合成紫杉醇的内生真菌,后来科学家又陆续从云南红豆杉、西藏红豆杉、南方红豆杉等多种红豆杉树种体内分离出了相关内生真菌,这表明内生真菌很可能具有合成和宿主植物相同或相似的活性成分的能力。近年来,越来越多的研究表明内生真菌确实可能具有这一能力:银杏的内生真菌裂褶菌发酵液和菌丝体能生产槲皮素;长春花分离得到的尖孢镰刀菌可培养产生长春新碱等,这些都是潜在的抗癌药物。
对于医药行业,这无疑是一个重大利好,因为内生真菌虽然以植物作为宿主,但它们同样可以离体培养,如果将这些内生真菌大规模工业化培养,我们还愁不能获取足够的药用化合物吗?未来,内生真菌很可能成为一个巨大的药物宝库。
在农业方面,内生真菌也能发挥重大作用。我们已经知道,内生真菌有抗病虫害的作用,其原因可能为产生抗生素类物质、水解酶、生物碱等物质杀灭病原菌,与病原菌竞争营养物质等。换句话说,当经济作物遭遇严重的病虫害时,内生真菌可以作为一种环保无害的“农药”帮助作物抵御病菌、害虫的侵扰。
这一切美好的前景都建立在对内生真菌更深入、更全面的研究之上,而种子库则可能满足这一需求。种子库储存着地球上几乎全部的植物物种的种子,其中所包含的内生真菌种类前所未有的丰富,其中绝大部分都还未被人类所认识,谁知道未来我们能从这个宝库中挖掘出什么宝藏呢?